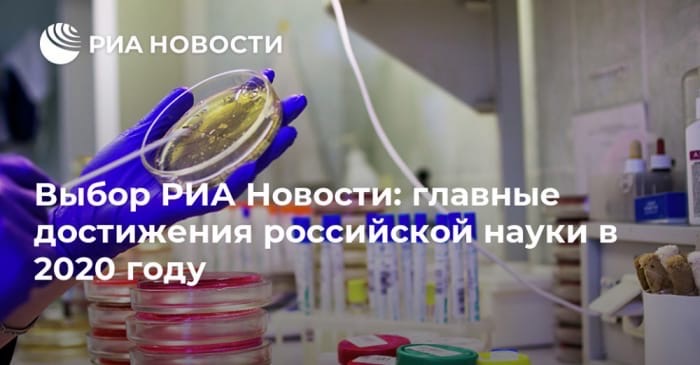

JINR achievements among best 2020 results according to RIA Novosti
News, 18 December 2020
On 16 December, the editorial board of the online portal RIA Novosti published a list of the milestones of Russian science of the outgoing year. The Joint Institute for Nuclear Research appears twice on this prestigious list.
The RIA Novosti Choice included work of JINR scientists as members of the Borexino collaboration that has recently obtained a bright result: scientists registered for the first time ever solar neutrinos thus confirming a theoretical prediction of the existence of an energy source of stars in the CNO-cycle. The prediction has been made several decades ago. Solar neutrinos are particles that are produced on the Sun as a result of the process called the CNO-cycle, in which carbon (C), nitrogen (N), and oxygen (O) turn into each other “spending” hydrogen and “producing” helium for it. Future studies in this realm will allow scientists to understand better the processes occurring in stars, in particular, to clarify the elemental composition of the Sun.
Moreover, the editorial board of RIA Novosti also highlighted the Booster superconducting accelerator having no analogues in the world, which is the first stage of the NICA complex, a flagship mega-science project of the Joint Institute. The launch of the Booster took place in November. Prime Minister of the Russian Federation Mikhail Mishustin launched the unique synchrotron during his visit to Dubna.
RIA Novosti Choice: main achievements of Russian science in 2020